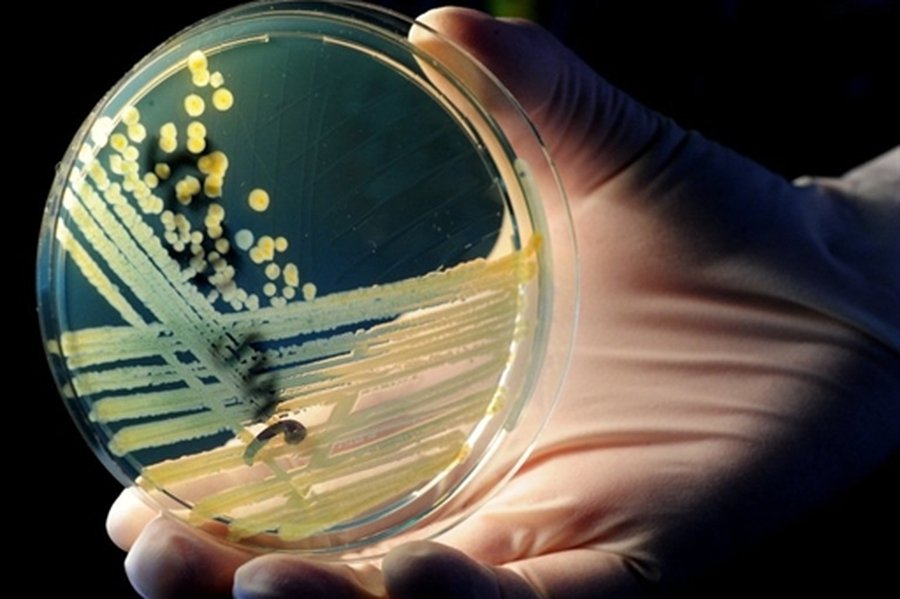
Следы смертельных овощей ведут в Германию - В Мире

Испанские огурцы оправданы. Однако число жертв кишечной инфекции в Европе продолжает расти. :::В Германии заявили, что на овощах из Испании обнаружен штамм кишечной палочки. Но это не тот вирус, который унёс жизни уже 16 человек.
Таким образом, поиск источника заражения придется начинать заново. В виновность испанской сельхозпродукции не верили в первую очередь сами испанцы. В стране выявлено только два случая отравления с похожими симптомами — у людей, недавно посетивших Германию. Чтобы доказать абсолютную безопасность овощей, министр сельского хозяйства Андалусии Клара Агилера съела огурец в прямом эфире.
«Вы не можете создавать такую панику, не имея точных данных об источнике заражения. А я уверена, этих данных нет ни у Германии, ни у Евросоюза», — сказала она.
Во вторник стало известно о первом случае смерти за пределами Германии. В Швеции скончалась женщина, которая недавно путешествовала по Германии. Новая жертва и в самой Германии — в госпитале Падерборна умерла 87-летняя пациентка. Всего в стране зафиксировано около 1200 случаев отравления, 400 человек находятся в тяжелом состоянии. Случаи заражения кишечной палочкой отмечены в Швеции, Нидерландах, Дании, Швейцарии и Великобритании.
mail.ru
Следы смертельных овощей ведут в Германию
Комментарии
Для комментирования необходимо войти в аккаунт Facebook (Meta)
В Мире
другие новости раздела →
Хрупкое перемирие на Ближнем Востоке нарушено

В противостоянии США и Израиля против Ирана достигнуто хрупкое перемирие

Андреюс Трофимовас: бизнес в Украине растёт даже во время войны

Андреюс Трофимовас: как автобусы из Литвы стали спасением для жителей охваченного огнём Мариуполя (фотогалерея)

СМИ: Иран озвучил свои требования по разблокировке Ормузского пролива

Трамп назвал примерные сроки военной операции против Ирана

США и Израиль нанесли серию военных ударов по территории Ирана
